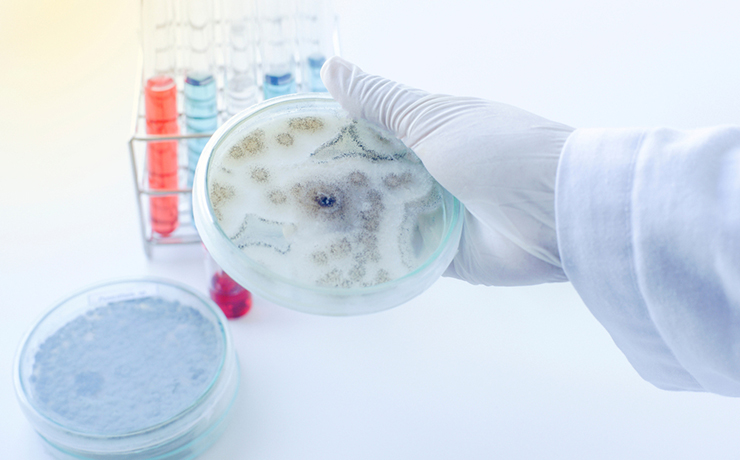
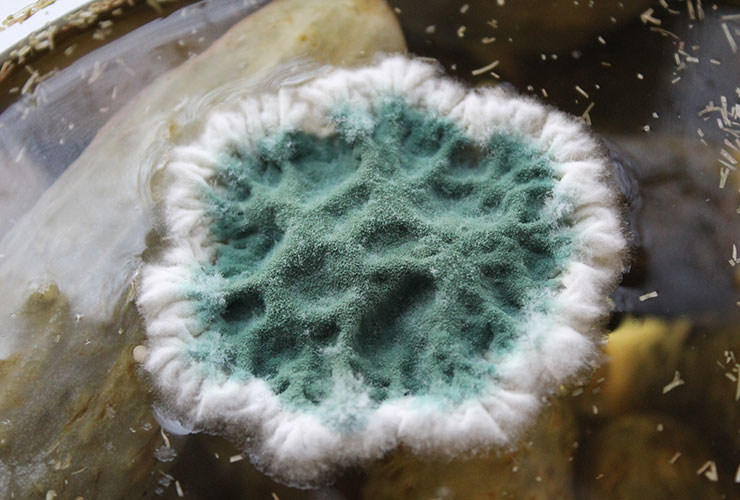

곰팡이란?

곰팡이는 보통 그 본체가 실처럼 길고 가는 모양의 균사로 되어 있는 사상균을 가리킨다. 일반적으로 균류 중에서도 세균·고초균·버섯 등이나, 경우에 따라서는 효모와도 구별하지만 엄밀하게 구별하기에는 어려움이 많다.
균류는 보통 다음과 같이 분류한다. 조균류 270속 1,500종, 자낭균류 1,850속 1만 5000종, 담자균류 550속 1만 5000종, 불완전균류 1,450속 1만 5000종, 그밖의 것을 포함하면 합계 4,400속 5만 종이 된다.
이 가운데서 버섯을 형성하는 것은 자낭균류의 일부와 담자균류가 대부분이므로 나머지는 모두 곰팡이류로 다루게 된다. 그러므로 곰팡이류의 종류는 아무리 적게 보아도 3만 종 이상이다.
대부분의 곰팡이류는 현미경으로 보면 세포가 길쭉해져 있고 또한 세로로 연결되어 실과 같은 모양을 하고 있다. 이것을 균사라고 한다. 곰팡이류 중에서 일생을 단세포로 마치는 것도 있다. 그러나 뚜렷한 세포핵을 가지고 있으며, 핵은 단핵·2핵·다핵인 것이 있는데, 특히 조균류의 것은 복잡한 모양의 전균체(全菌體)가 격벽 없는 다핵의 단세포체를 이루고 있다.
곰팡이류는 온난다습한 환경을 좋아하며 최적온도가 30℃ 정도인데, 그 중에는 5∼8℃인 냉장고 속의 육류에 가장 잘 발생하는 카에토스더리움도 있고, 푸른곰팡이의 어떤 종은 45∼53℃에서만 자라는 것도 있다
곰팡이 주요 발생장소와 원인
- 곰팡이 주요 발생장소 : 베란다 및 벽, 습기가 많은 곳
- 곰팡이가 생기는 원인 : 단열이 취약해서 결로로 인한 곰팡이, 환기 부족으로 인한 곰팡이

곰팡이 원인 파악
곰팡이가 발생한 곳을 청소하는 것 뿐만 아니라 곰팡이의 발생 원인을 파악하여 곰팡이 제거 후에도 곰팡이가 발생되지 않도록 고객님께 정확하게 안내해 드립니다.

친환경 제품 사용
친환경 곰팡이 제거제를 사용하여 고객님과 가족의 건강에 영향이 없도록 하여 곰팡이를 효과적으로 제거하게 됩니다.
나노팡 (곰팡이예방)
사용처 : 병원/학교/식당/회사/공장/주방/베란다/화장실 등

| 제품명 | 나노팡 |
|---|---|
| 품목 | 코팅제 |
| 용도 | 실내용, 차량용, 침구용(곰팡이 예방제) |
| 함유성분 | 산화티탄, 은이온, 초순수수 |
| 사용처 | 화장실/침구일체/가구/장난감/핸드폰 살균/병원/학교/식당/새집증후군이 필요한 공간/악취 및 유해물질 제거 |
차원이 다른 곰팡이 예방제
기존의 락스 계열이 아닌 곰팡이 예방제로 나노의 우수성으로
한번 시공 후 오랜 시간 동안 예방 할 수 있다.

곰팡이 포자 이제 끝!
곰팡이의 포자가 터지면서
집안 곳곳에 번지는 것을 예방한다.

바이러스의 진드기 방제 작용
은의 항균 작용에 의하여 바이러스 방지 뿐만 아니라
좀, 집 먼지 진드기 발생 억제해 아토피에 좋습니다.

곰팡이의 불쾌한 냄새 제거
곰팡이가 발생되지 않으므로
비릿한 곰팡이의
특유한 냄새가 발생하지 않도록 예방한다.
곰팡이제거 추천대상
- 곰팡이가 발생한 아파트,빌라,원룸 등
- 베란다,다용도실 등의 밀폐된 환경
- 지하실, 연습실 등의 지하공간
- 마루,데코타일등에 발생한 곰팡이균
- 결로현상으로 곰팡이가 발생되는 곳
- 고객들이 방문하는 상업,숙박시설

가족울터 시공프로세서
1.전화상담
고객상담으로 견적과 일정 안내
2.현장방문
서비스가 필요한 현장 방문
3.현장확인
현장의오염도와 상황을 점검
4.곰팡이 제거
전용세제와 장비로 청소작업진행
5.결로방지 &
곰팡이 예방제 코팅
'나노팡' 곰팡이 예방제 코팅
6. 점검작업
청소완료 후 전체적인 청소점검
7. 고객확인
고객 검수를 끝으로 서비스 종료
가족울터